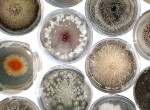
Fungal cultures on petri dishes. Credit: Rowena Hill

2021
Study offers new insights into the timeline of mammal evolution22 December 2021
A new study, published today in the journal Nature, has provided the most detailed timeline of mammal evolution to date.
Risk factors for heart disease change heart structure and appearance22 December 2021
A new study led by researchers at Queen Mary University of London suggests that certain risk factors for heart disease are linked to common changes in the structure and appearance of the heart.
Queen Mary professor awarded Major Research Fellowship from the Leverhulme Trust17 December 2021
The Fellowships are given to well-established, distinguished researchers in the humanities and social sciences to support them to complete original programmes of research.
Scientists create stable materials for more efficient solar cells15 December 2021
Researchers from Queen Mary University of London have developed a new process for producing stable perovskite materials to create more efficient solar cells.
Queen Mary announces winners of Education Excellence Awards15 December 2021
Queen Mary has recognised and celebrated inspired teaching and support for students across the University at its annual Education Excellence Awards and President and Principal’s Prizes.
New insights into impact of multiple sclerosis treatments on Covid-19 vaccine effectiveness 15 December 2021
Treatments used to help people with multiple sclerosis (MS) manage their condition can reduce the effectiveness of Covid-19 vaccines, according to research from Cardiff University and Queen Mary University of London
Queen Mary academic wins American Association of Geographers’ Creativity Award15 December 2021
Professor Kathryn Yusoff from Queen Mary’s School of Geography has been awarded the 2022 Brunn Creativity Award by the American Association of Geographers.
Queen Mary's Clinical Effectiveness Group receives funding to tackle falling pre-school immunisation rates14 December 2021
Four projects tackling some of London’s key health challenges have been awarded a total of £1 million to demonstrate how the use of data at scale can improve health outcomes, supporting delivery of the London Health Data Strategy.
New online training platform builds global expertise in trauma research14 December 2021
Researchers from Queen Mary University of London are helping to develop trauma frontline professionals as part of an international collaboration with Thailand’s Thai Siriraj Medical School and Mahidol University.
Queen Mary climbs 47 places in sustainability league table14 December 2021
Queen Mary University of London has risen 47 places, from number 83 to 36 in the 2021 People & Planet University League.
Queen Mary academic wins major prize for Black British playwriting10 December 2021
Dr Mojisola Adebayo from the School of English and Drama was awarded the Alfred Fagon Award for her play Family Tree.
More diversity improves genetic research into cardiovascular disease, according to new study 8 December 2021
A new study, co-led by Queen Mary University of London, has made the case for more diversity in genetic research.
Entelechy Arts and Queen Mary University of London launch a new report on how to deliver remote arts programmes for older adults 8 December 2021
A new report based on research led by Entelechy Arts and Queen Mary University of London will provide insights into how arts organisations can design and deliver remote programmes, based on experiences during the Covid-19 pandemic.
Queen Mary and Newham College to launch new Institute of Technology8 December 2021
Queen Mary University of London and Newham College have announced the launch of the London City Institute of Technology (LCIoT) - a partnership involving a range of leading names from the world of business that will offer world-class training and education and provide the skills that employers need to keep London moving forward as a leading global city.
Molecule found in seafood plays role in protecting and improving cognitive function, researchers find7 December 2021
A molecule found in high quantities in fish and other seafood could play a role in protecting and improving cognitive function in the brain, a new study suggests.
Immune imprinting causes varied patterns of protection against COVID-19 variants3 December 2021
New research shows that the first SARS-CoV-2 spike protein a person encounters, be it by vaccination or infection, shapes their subsequent immune response against current and future variants.
Queen Mary student wins ‘Best doctoral or early career film of the year’ at the AHRC Research in Film Awards3 December 2021
Alex Widdowson, a Doctoral Researcher within the Department of Film, received the award yesterday for his investigation into the ethical issues associated with the representation of autism in film.
Joint Queen Mary-National Polytechnic Institute ‘SAPIENS’ workshop focuses on smart air pollution forecasting system 3 December 2021
A research project developing a proof-of-concept air quality prediction system to provide hyper-local, dynamic air quality forecasts for Mexico City was the focus of the SAPIENS Queen Mary-National Polytechnic Institute of Mexico (IPN) international workshop held on 22 November 2021.
Queen Mary academics secure major funding from the National Institute for Health Research3 December 2021
A team of academics from Queen Mary University of London have successfully secured funding for a major research project led by Professor Andrew Prendergast from Queen Mary’s Blizard Institute and Dr Bwakura-Dangarembizi from the University of Zimbabwe.
Queen Mary wins first-ever Platinum award for Public Engagement2 December 2021
Queen Mary University of London has become the first university to be awarded the Platinum-level Engage Watermark in recognition of its sector-leading support for public engagement and commitment to excellence. This is the first award of its kind in the UK and attests to the University’s reputation for excellence in its public engagement work. Queen Mary was also the first university to be awarded a Gold Engage Watermark in 2016.
Queen Mary academic wins best business book proposal prize2 December 2021
Dr Eileen Tipoe, a Senior Lecturer in the School of Economics and Finance was announced as the winner of the Financial Times and McKinsey’s 2021 Bracken Bower Prize. The Prize is awarded to the best business book proposal by an author aged under 35.
Allergic conditions linked to lower Covid-19 infection risk2 December 2021
New research from Queen Mary University of London sheds new light on the risk factors for developing Covid-19.
Reducing sodium and increasing potassium may lower risk of strokes and heart disease30 November 2021
A recent study, involving researchers from Queen Mary University of London, provides further evidence that lower salt consumption and higher potassium intake is linked with lower risk of strokes and heart disease.
World Aids Day – Improving the lives of everyone affected by HIV30 November 2021
As we mark 40 years since the first reported cases of HIV-related illnesses and deaths, we can see that HIV treatment and care has come a long way since the times when being diagnosed with HIV was a death sentence.
New book explores key issues around intellectual property rights30 November 2021
A new book co-edited by an academic from Queen Mary University of London brings together international experts to discuss the framework within which intellectual property (IP) laws are made around the globe.
Queen Mary celebrates 50 years of Materials 29 November 2021
On Friday 5 November, Queen Mary University of London celebrated 50 years of Materials graduates in London and the first cohort from Queen Mary Engineering School at Northwestern Polytechnic University (NPU) in China.
New £11.6 million PhD Programme for health research in underrepresented populations
29 November 2021
The Health Advances in Underrepresented Populations and Diseases (HARP) PhD Programme focuses research towards people and diseases that have traditionally been underrepresented in healthcare studies.
Scientists discover gut bacteria that improve memory in bees25 November 2021
An international research team have discovered a specific type of gut bacteria in bees that can improve memory.
Building inclusion through flexible and resilient education systems24 November 2021
Following receipt of a major award from Advance HE’s Collaborative Development Fund, Queen Mary Academy is now publishing its final report into developing agile and responsive education and training across the Higher Education (HE) sector.
Queen Mary named best university in the country for social mobility23 November 2021
Queen Mary University of London has been ranked as the country’s top university for social mobility, according to a new report by the Institute for Fiscal Studies in partnership with the Sutton Trust and Department for Education.
Queen Mary Professor elected to UN International Law Commission22 November 2021
Professor Phoebe Okowa has been successfully elected to the International Law Commission, following her nomination by the Government of Kenya earlier this year. She was also jointly nominated by the Government of the United Kingdom. She obtained 162 votes in the General Assembly.
Sadiq Khan delivers 9th George Lansbury Memorial Lecture19 November 2021
The Mayor of London, Sadiq Khan, delivered this year’s Memorial Lecture, organised by the George Lansbury Memorial Trust, in honour of the former Labour leader at Queen Mary University of London on Wednesday 18 November.
Queen Mary researcher discovers rare manuscript fragments hidden in library18 November 2021
Dr Tamara Atkin, an English literature specialist and book historian from Queen Mary University of London, has discovered two rare manuscript fragments hidden away in a 16th-century book in the Bodleian Library in Oxford. One tells part of the story of Tristan and Iseult, among the most famous star-crossed lovers of Middle Ages. The other is a fragment of a long-lost poem that scholars had thought to exist but had yet to find anywhere.
Brief 5:2 diet advice is as effective as traditional GP advice, but people like it better17 November 2021
A clinical trial has found people prefer receiving information on the 5:2 diet than standard GP weight management advice despite both interventions achieving similar modest weight loss results.
Queen Mary joins Tower Hamlets partnership towards a Net Zero Carbon borough12 November 2021
Together, Queen Mary, Tower Hamlets Council and other partners including the Canary Wharf Group and New City College are joining forces to achieve net zero carbon by 2045 or sooner through the Net Zero Carbon Partnership Action Plan.
Queen Mary’s Isabel Waidner wins Goldsmiths Prize12 November 2021
Dr Isabel Waidner, author and Senior Lecturer in Creative Writing/Performance at Queen Mary University of London, won the award for their novel Sterling Karat Gold at a ceremony on Wednesday 10 November.
Queen Mary University of London expands partnership with leading law firm Mishcon de Reya12 November 2021
Queen Mary’s School of Law has strengthened its longstanding partnership with leading law firm Mishcon de Reya LLP, which has generously pledged a donation of £100,000 spread over four years to sponsor ‘The Mishcon de Reya LLM Scholarship’ at the Centre for Commercial Law Studies (CCLS).
Blood test predicts which prostate cancer patients are resistant to chemotherapy drug11 November 2021
Research conducted at Queen Mary University of London, indicates that regular blood tests before and during chemotherapy for prostate cancer can detect whether or not a patient is resistant or developing resistance to treatment with a drug called docetaxel.
Queen Mary invests in Humanities and Social Sciences with 25 new academic posts11 November 2021
Queen Mary University of London marks a major investment in Humanities and Social Sciences with a set of new lecturer and senior lecturer roles.
Whole genome sequencing improves diagnosis of rare diseases and shortens diagnostic journeys for patients10 November 2021
A world-first scientific study, published today in the New England Journal of Medicine, has shown that whole genome sequencing (WGS) can uncover new diagnoses for people across the broadest range of rare diseases investigated to date and could deliver enormous benefits across the NHS.
New target for Covid-19 vaccines identified10 November 2021
Next generation vaccines for Covid-19 should aim to induce an immune response against ‘replication proteins’, essential for the very earliest stages of the viral cycle, according to a new study involving Queen Mary University of London researchers, Professor Aine McKnight, Dr Corinna Pade and Joseph Gibbons.
Call for Removal of Misleading Sugar Claims on Baby & Toddler Sweet Snacks such as Biscuits and Rusks10 November 2021
A new product survey by Action on Sugar - based at Queen Mary University of London - has exposed the alarming amounts of sugars found in many baby & toddler sweet snacks such as biscuits, rusks, oat bars and puffs. With some products containing a massive two teaspoons of sugar per serve, this is of deep concern considering babies and toddlers should not be eating any free sugars at all. In fact, children aged between the ages of 1.5 and 3 years are exceeding 27.9g (equivalent of 7 teaspoons) of free sugars per day, according to the National Diet and Nutrition Survey.
Queen Mary at the United Nations Climate Conference (COP26)9 November 2021
Queen Mary University of London’s engagement and expertise has been on show in Glasgow as world leaders, non-government organisations and activists gathered for the UN Climate Conference known as COP26.
Queen Mary academic nominated for best business book proposal prize9 November 2021
Dr Eileen Tipoe, a Senior Lecturer in the School of Economics and Finance has been shortlisted for the Financial Times and McKinsey’s 2021 Bracken Bower Prize. The Prize is awarded to the best business book proposal by an author aged under 35.
New app helps parents identify treatable childhood growth disorders earlier8 November 2021
A new mobile phone app, ‘GrowthMonitor’, places the accurate measurement of children’s height in the hands of parents and carers.
Queen Mary Professor elected to Germany’s National Academy of Sciences8 November 2021
Professor Lars Chittka from Queen Mary University of London has been elected to the prestigious German National Academy of Sciences Leopoldina.
Multiple factors contribute to COVID-19 vaccine hesitancy among older, ethnic minorities
5 November 2021
A new study involving Queen Mary University of London suggests patient-related factors, healthcare providers, health systems and policy may facilitate access or barriers to vaccination.

4 November 2021
Professor Carol Dezateux and Nicola Firman from Queen Mary University of London have co-written a piece for The Conversation on a recent study published in The Lancet, which found that the HPV vaccine cuts cervical cancer cases by nearly 90 per cent, and their research on the takeup.
Queen Mary celebrates Bangladesh’s Independence through Freedom and Independence Theatre Festival4 November 2021
Queen Mary has partnered with Tower Hamlets Council to celebrate 50 years of Bangladeshi independence with The Freedom & Independence Theatre Festival.
Study reveals ‘drastic changes’ in daily routines during UK lockdowns 4 November 2021
New research by Queen Mary University of London and the University of Cambridge, published in PLOS ONE, shows that some spent an extra hour a day on chores and childcare during lockdown, while others got an added daily hour of solo leisure time – and most of us reduced time spent on paid work by around half an hour a day.
New book offers in-depth look at how the 2019 general election turned into a triumph for the Tories and a tragedy for Labour3 November 2021
Co-authored by Tim Bale, Professor of Politics at Queen Mary University of London, The British General Election of 2019 provides readers with the most detailed look into one of the most consequential and controversial general elections in recent times.
Queen Mary University of London takes major stake in Whitechapel Life Sciences development 2 November 2021
Queen Mary University of London has agreed a property deal with the Department of Health and Social Care (DHSC) that paves the way for the development of a state-of-the-art life sciences centre and supports DHSC plans for a Whitechapel Life Sciences Cluster.
Queen Mary academics collaborate for review into energy and climate change29 October 2021
The Energy and Climate Change Law Institute, a leading postgraduate law school within the Centre for Commercial Law Studies at Queen Mary, has published its Law Review exploring the legal and technical issues involved in securing effective progress towards net zero.

27 October 2021
Dr Reuben Loffman, Senior Lecturer in African History at Queen Mary has written for The Conversation on Félix Tshisekedi, president of the Democratic Republic of Congo, and the need for a programme of change that delivers for the Congolese people now that he has a firm grasp on politcal power.
Female leadership is vital to managing climate change, according to Emma Howard Boyd27 October 2021
The Chair of the Environment Agency spoke at Queen Mary’s Energy & Climate Change Law Institute Annual Clifford Chance Lecture on October 21st, delivering a talk on the role of women in managing climate change.
Queen Mary alumnus wins prestigious poetry award27 October 2021
Caleb Femi, who graduated from Queen Mary University of London with a degree in English in 2013, was one of the recipients of the Forward Prizes for Poetry.
Queen Mary commits to Tower Hamlets’ anti-racist pledge26 October 2021
Queen Mary University of London has formally signed up to Tower Hamlets’ Anti-Racist Pledge, as part of the University’s continued efforts to challenge racial inequality and ensure staff and students can work and learn in a racism-free environment.
New artificial intelligence offers hope for liver cancer patients with less than 13 per cent chance of survival25 October 2021
Researchers at Queen Mary University of London and King’s College Hospital have shown that a new computer-based algorithm can rank drugs used to treat primary liver cancer, based on their efficacy in reducing cancer cell growth.
Queen Mary research features in new Science Museum Group exhibition on cancer25 October 2021
A research project led by Professor Fran Balkwill from Queen Mary University of London's Barts Cancer Institute (BCI) features in a world-first free exhibition exploring the revolution in science that is transforming cancer care.
Research breakthrough could mean better treatment for patients with most deadly form of brain tumour21 October 2021
Scientists studying the most common and aggressive type of brain tumour in adults have discovered a new way of analysing diseased and healthy cells from the same patient.
Queen Mary academic wins prestigious Leverhulme Trust research award20 October 2021
Dr Martin O’Brien from the School of English and Drama has been announced as a winner of the 2021 prize.
Winners of the 2021 Queen Mary Wasafiri New Writing Prize announced19 October 2021
The winners of the Queen Mary Wasafiri New Writing Prize 2020 include authors from the UK, Ireland, and India.
Queen Mary supports Tower Hamlets with Covid-19 commemoration ceremony19 October 2021
Queen Mary University of London held a ceremony in recognition of the local community’s efforts against Covid-19 and to mark the pandemic’s impact.
Queen Mary hosts local young people as they tackle health inequality18 October 2021
Health Pioneers, a charity founded by local doctors and educators, empowers teenagers in East London to boost their own health education - and spread the word
People’s happiness levels show recession is coming, warns renowned economist David Blanchflower18 October 2021
The wellbeing of the average man or woman on the Mile End Road omnibus – their thoughts, feelings, worries and anxieties – currently suggests an incoming recession in the UK and is the very best indicator around, according to noted economist David ‘Danny’ Blanchflower.
Queen Mary University of London launches new degree apprenticeship18 October 2021
The School of Electronic Engineering and Computer Science at Queen Mary University of London has developed a new employee partnership with PricewaterhouseCoopers (PwC) for students studying the Digital and Technology Solutions (Data Analyst) Level 6 Degree Apprenticeship programme. Applications are now open for September 2022 entry.
Queen Mary launches Sustainability Week to boost climate awareness18 October 2021
Queen Mary University of London is holding a ‘Sustainability Week’ during the week of 18 October, to highlight the risks associated with climate change and other major environmental challenges.
Queen Mary reuniting Stepney Words poets for 50th anniversary event15 October 2021
Queen Mary University of London professor Nadia Valman and BBC journalist Alan Dein are reuniting Chris Searle – the teacher at the centre of the extraordinary Stepney Words story and subsequent protests across London – with some of the original Stepney Poets. The reunion will mark the significance and legacy of Stepney Words and recognise the continuing radical potential of poetry in east London, as part of the Being Human festival.
Queen Mary study wins ‘Research Paper of the Year’ award14 October 2021
A study led by Queen Mary University of London has today been announced as the overall winner of the Royal College of General Practitioners Research Paper of the Year award.

14 October 2021
Professor Tim Bale from the School of Politics and International Relations has co-written an article for The Conversation analysing western Europe's centre right, looking at recent election results and trends in Germany and other nations.
Queen Mary partners with Health Education England to launch new medical degree pilot 12 October 2021
Prospective medical students in England will soon be able to choose to study flexibly thanks to a new pilot scheme launched by Health Education England and delivered by Queen Mary University of London.
Queen Mary launch storytelling workshops to inspire engineering students 12 October 2021
Students from Queen Mary University of London’s School of Engineering and Materials Science have been coached by world-class storytellers and creatives as part of an exciting new project.
Queen Mary partner with industry to train next generation of ‘AI-native’ biological scientists 12 October 2021
Queen Mary University of London are partnering with Exscientia, MSD and Heptares Therapeutics to deliver a new doctoral training programme that will train researchers to apply cutting-edge AI expertise to the discovery and development of new drugs.
Queen Mary researchers launch new project to support rewilding8 October 2021
Queen Mary University of London researchers have partnered with pioneering lowland rewilding site Knepp Wildland on a project that will help rewilding efforts up and down the country.
Queen Mary academic and author shortlisted for prestigious Goldsmiths Prize8 October 2021
Dr Isabel Waidner, author and Senior Lecturer in Creative Writing/Performance at Queen Mary University of London, has received the recognition for their novel Sterling Karat Gold.
Mathematical model offers new insights into spread of epidemics7 October 2021
Mathematical models have been widely used to guide government decisions on the Covid-19 pandemic, from forecasting outcomes to even testing potential interventions.
New study supports call for mandatory front-of-pack labelling to improve diets6 October 2021
A new systematic review and meta-analysis led by researchers from Action on Salt and Sugar based at Queen Mary University of London supports the call for mandatory front-of-pack nutrition labels in directing consumers towards healthier options.
Queen Mary’s stop smoking service expands to Waltham Forest4 October 2021
Experts from Queen Mary University of London have launched a stop smoking service to deliver advice and support for people in the London Borough of Waltham Forest.
Queen Mary cements partnership with the Huazhong University of Science and Technology1 October 2021
Queen Mary University of London has signed a partnership agreement with the Wuhan-based Huazhong University of Science and Technology (HUST) in a move that will create opportunities for collaboration and open doors to students, researchers and staff.

30 September 2021
Dr Karl Pike, Lecturer in British Politics/Public Policy at Queen Mary University of London has written for the Conversation on Keir Starmer's speech at the Labour Party Conference in Brighton.
Queen Mary researcher translates Marquis de Sade novel into English for the first time30 September 2021
Dr Will McMorran, a world-leading expert on the Marquis de Sade at Queen Mary University of London has translated the infamous author’s The Marquise de Gange into English for the very first time for Oxford World’s Classics.
Two new species of large predatory dinosaur discovered on Isle of Wight28 September 2021
A new study, involving Queen Mary University of London, suggests that bones found on the Isle of Wight belong to two new species of spinosaurid, a group of predatory theropod dinosaurs closely related to the African giant Spinosaurus.
Young children from England’s poorest areas are shorter, according to new Queen Mary study28 September 2021
Primary school children from England’s most deprived areas are nearly twice as likely to be short than those in the least deprived areas, according to new research led by Queen Mary University of London.

28 September 2021
Professor Tim Bale from Queen Mary's School of Politics and International Relations has written for the Conversation on this year's Labour's Party Conference.
Queen Mary researcher develops new abortion support resource28 September 2021
Queen Mary University of London researcher Dr Sydney Calkin has developed a new online resource so that people across Europe can safely access abortion services when they are unable to in their own country. It was developed in collaboration with the Abortion Support Network. Countries include Poland, Ireland and Malta – in response to particularly high levels of need in some locations.
Queen Mary awarded funding for new Primary Care Research Fellowships 25 September 2021
Queen Mary has received funding for three fellowships in primary care as part of our membership in the National Institute of Health Research (NIHR) School for Primary Care Research (SPCR).
Queen Mary student nominated for two AHRC research awards24 September 2021
Queen Mary University of London PhD candidate Alex Widdowson in the Department of Film Studies has been nominated for both the Best Doctoral or Early Career Film of the Year and Best Animated Film of the Year awards by the Arts and Humanities Research Council (AHRC).
Launch event held for Queen Mary professor’s book on Irish political prisoners22 September 2021
Professor Seán McConville of Queen Mary University of London appeared alongside Minister James Browne - Minister of State at the Department of Justice – and Professor Eunan O’Halpin of Trinity College Dublin at a launch event in Dublin yesterday evening for Professor McConville’s book Irish Political Prisoners 1960-2000: Braiding Rage and Sorrow.
New report urges reforms to give families better access to the digital assets of deceased loved ones21 September 2021
Families need better support from social media companies and the government when it comes to accessing the digital assets of ill or deceased loved ones, according to the Cloud Legal Project at Queen Mary University of London and STEP.
Queen Mary a winner at Pearson’s inaugural HE Innovate Awards20 September 2021
Queen Mary University of London has won the award for ‘Most innovative hybrid or blended learning project’ at the first ever HE Innovate Awards.
Queen Mary’s People’s Palace Projects research sheds light on violence and mental health in Brazilian favelas17 September 2021
Favela residents with more personal experience and fear of violence have higher levels of mental distress and poorer quality of life, according to the main finding of the international research Building the Barricades.
Queen Mary opens new building designed for modern working17 September 2021
Queen Mary University of London has opened its doors to Dept W – its new building for professional services staff fully designed specifically for agile working.
Queen Mary researcher awarded medal for outstanding contributions to space science 15 September 2021
Dr Chris Chen from Queen Mary University of London has won American Geophysical Union’s James B. Macelwane Medal for his significant contributions to the geophysical sciences as an early career scientist.
Queen Mary Professor appointed as President of UK’s leading organisation for women doctors14 September 2021
Professor Chloe Orkin from Queen Mary University of London has been appointed as President of the Medical Women’s Federation.

14 September 2021
Benedetta Zocchi, Leverhulme Trust Doctoral Scholar at Queen Mary University of London has written for The Conversation recounting the harrowing testimonials from Afghans on the Bosnian border.

13 September 2021
Dr William Monteith, Senior Lecturer in Human Geography at Queen Mary University of London has written for The Conversation on the concept of work and the need to reimagine it based on the experiences of the global majority.
UK lung cancer trial shows screening at-risk groups lowers mortality rates 13 September 2021
Results from the UK Lung Screening Trial (UKLS), the first lung cancer CT screening trial in the UK, have provided unequivocal support for lung cancer screening in identified high risk groups.
Insight into power generation in photosynthesis may lead to more resilient crops10 September 2021
A study into the energy-making process in plants could help engineer crops more resistant to stress or bacteria that produce pharmaceuticals.
New study shows 9/11 prepared firms for economic effects of COVID-199 September 2021
A new study involving a Queen Mary University of London researcher has shown companies that experienced the financial impact of 9/11 were more resilient to the economic effects of COVID-19.
Queen Mary students provide valuable insight into European superyacht industry8 September 2021
Queen Mary University of London students Katharina Pietsch and Benedikt Hülsmann have completed a research project – funded and requested by MYBA, The Worldwide Yachting Association – that investigates the economic contribution of the superyacht industry in European countries.
Scientists discover chemical signals in starfish that stop them eating7 September 2021
Like humans, starfish produce chemicals that tell them they’re full and to stop eating, according to a new study published today in the journal eLife.
New paper urges clinics to take responsibility for what IVF add-ons they offer and how6 September 2021
A new study by Queen Mary University of London, published in Social Science and Medicine warns both private and publicly funded clinics should take responsibility for what IVF add-on treatments they offer and how these are framed to patients.
New study involving Chemical Engineering students could help produce high-quality drinking water at lower cost3 September 2021
An international research collaboration involving students and researchers from Queen Mary University of London provides new insights to help improve drinking water treatment processes.

31 August 2021
Farah Hussain, PhD Researcher from the School of Politics and International Relations at Queen Mary University of London has written for The Conversation on whether Labour can build electoral support among Muslim communities.
New study shows intervention alone does not decrease post-surgery deaths in Africa24 August 2021
A new study from a team of researchers, including from Queen Mary University of London, has provided valuable insight into reducing death following surgery in African hospitals. It found that intervention methods alone, such as having nurses conduct more regular checks of patients or placing patients in a higher care ward, are not enough to bring down the number of deaths.
Queen Mary University of London professors awarded prestigious medals by the Royal Society24 August 2021
The Royal Society is a Fellowship of many of the world's most eminent scientists and is the oldest scientific academy in continuous existence.
Queen Mary campuses help preserve one of Britain’s rarest trees19 August 2021
Queen Mary University of London President and Principal Colin Bailey has taken part in planting a Black Poplar – one of Britain’s rarest trees – on the University’s Mile End campus.
Call to Stop Misleading Parents with Child Friendly Packaging and Health Claims on Children’s Yogurts as Only 1 in 20 Contain ‘Healthy’ Sugar Levels19 August 2021
Progress to reformulate and reduce added sugar in yogurts with child friendly packaging (and in line with government guidance) is disappointingly sluggish, according to research carried out by Action on Sugar based at Queen Mary University of London.
New study reveals patients from minority ethnic groups are more likely to be admitted to hospital 19 August 2021
Patients from minority ethnic groups have a disproportionately higher rate of emergency hospital admissions, according to research by Queen Mary University of London and Barts Health NHS Trust.
Queen Mary spinout Nemisindo launches online sound design service based on procedural audio technology 18 August 2021
Queen Mary University of London spinout Nemisindo are launching a new online service that will allow users to create sound effects for games, film and VR without the need for vast libraries of sounds.
Researchers uncover new evidence that fetal membranes can repair themselves after injury18 August 2021
Scientists from Queen Mary University of London and UCL have shown that fetal membranes are able to heal after injury in a new study published today in Scientific Reports.
Researchers successfully identify new gene variants that cause hypertension in pregnant women13 August 2021
An international study, led by researchers from Queen Mary University of London and St Bartholomew’s Hospital, has found a unique pair of gene variants that causes sudden onset high blood pressure in pregnant women.
Queen Mary’s Digital Environment Research Institute hosts first Fintech event
13 August 2021
Queen Mary’s new Digital Environment Research Institute (DERI) recently hosted their first industry-focused event with leading London financial technology companies.
Queen Mary part of international research collaboration to prevent spread of Covid-19 and TB in India12 August 2021
Queen Mary University of London is part of a new international research collaboration that aims to develop low-cost air sanitisation technologies to stop the spread of airborne diseases such as tuberculosis and Covid-19 in indoor spaces.
Queen Mary student wins award for learning disability-inclusive work11 August 2021
The SEED award, which stands for Student Enhanced Engagement and Development, is awarded by the Queen Mary Academy to students who apply and are registered at Queen Mary University of London each year to recognise their important contribution in shaping and co- creating education at the University.

11 August 2021
Dr Rachel Bryant Davies, Lecturer in Comparative Literature has written for The Conversation on how looking at historical playful learning can help us moving forward.

9 August 2021
In response to recent discussions about social media and racism, the Queen Mary Legal Advice Centre and legal firm Mishcon de Reya have published a joint editorial piece tackling the issue of anonymity online.
Dentistry students win Gold Medal in prestigious head-to-head competition9 August 2021
Recent Dentistry graduates from Barts and The London School of Medicine and Dentistry, Queen Mary University of London, have won all three prestigious University of London Gold Medal 2021 awards.

6 August 2021
Supported by a European Research Council (ERC) Starting Grant, Queen Mary researcher, Dr Tessa Baker, is aiming to develop new statistical techniques to identify how the laws of gravity governing the universe are different to those on earth.
Preventing Plastic Pollution project helps Team GB athletes to kick plastics out of sport5 August 2021
Queen Mary University of London is working in partnership with 18 organisations from across France and England to reduce the impact of plastic pollution on the marine environment. As part of the project, Team GB athletes have been invited to make a pledge to tackle plastic pollution.

4 August 2021
In this blog post, Dr Jahnavi Daru, Clinical Lecturer in Obstetrics and Gynaecology, discusses her latest research showing the vast differences in iron treatments that are available for pregnant women with anaemia. Reflecting on her current experience as a pregnant woman and obstetrician, she highlights the need for open and transparent discussions between patient and clinician on the range of treatments that may be available.
Queen Mary’s Summer Book and TV Musts30 July 2021
We can all agree on the benefits of an engaging book or TV series. Our academics regularly author books on a number of fascinating topics, and one of our students is currently starring in a hit TV show. Each of the below will certainly captivate you over the summer.

28 July 2021
Professor Joshua Reiss from Queen Mary's School of Electronic Engineering and Computer Science has written for The Conversation on the audio history of the Olympics and Covid-19's impact on Olympic sound design.
Queen Mary launches partnership with Rotary International to improve education and research in Pakistan27 July 2021
Queen Mary University of London has entered into a prestigious partnership with the Rotary Club of Karachi. In signing the Memorandum of Understanding, Queen Mary will jointly improve access to education in Pakistan and help young people improve not only their lives, but potentially those of generations to come.
Queen Mary academics elected to the British Academy23 July 2021
Two academics from Queen Mary University of London, Professor Galin Tihanov, and Professor Amanda Vickery, have been elected to the British Academy Fellowship in recognition of their contribution to the humanities and social sciences.
New report reveals the harsh reality of life for the UK’s migrant communities22 July 2021
A new report produced by Queen Mary University of London and the Racial Justice Network has revealed that a toxic combination of government policy, Brexit and the pandemic have had a devastating impact on migrant communities particularly accessing life saving medical treatment, mental health services and food.
Queen Mary professor receives prestigious Dentistry Gold Medal21 July 2021
The International Association for Dental Research (IADR) has announced Professor David Williams, Barts and The London School of Medicine and Dentistry, Queen Mary University of London, as the 2021 recipient of the IADR Gold Medal Award.
Bank of England must spell out risks of quantitative easing, according to new report21 July 2021
The House of Lords Economic Affairs Committee has published its report on the policies of the Bank of England. An academic at Queen Mary University of London acted as Special Advisor to the group, providing expert evidence, which informed the findings.
Genetics study in Pakistani and Bangladeshi communities will take action on health inequality20 July 2021
This Eid, Social Action for Health and Queen Mary University of London are calling on Bangladeshi and Pakistani communities to take part in world’s largest genetics study into people of their heritage, to help scientists understand and treat the causes and consequences of poor health.
Queen Mary researchers to study the link between physical and mental health19 July 2021
Researchers from the Genes & Health programme at Queen Mary University of London have received significant funding for an international collaborative project to better understand why some people develop multiple chronic health conditions.

16 July 2021
Professor Kate Spencer from Queen Mary's School of Geography has co-written an opinion piece for The Conversation on landfills and the need to address their role in leaking toxic chemicals into the ocean.
Scientists create rechargeable swimming microrobots using oil and water15 July 2021
A new study, published today in Nature Physics, has shown that it is possible to create tiny, self-powered swimming robots from three simple ingredients.
Queen Mary researchers win grant to establish the first onshore wave energy converters to power Thailand’s remote islands15 July 2021
Researchers at Queen Mary University of London have been awarded around £300,000 from Innovate UK to develop the first microgrids powered by onshore wave energy converters (WECs).
Lateral flow tests are 95% effective at detecting Covid-19 when used at the onset of symptoms14 July 2021
A new study by researchers at Queen Mary University of London, University of Oxford, Institute for Advanced Studies, Vienna, and the Medical University of Graz, has found that lateral flow tests detect Covid-19 with similar accuracy to laboratory-based PCR tests, providing they are used at the onset of infection and soon after symptoms start.

13 July 2021
Professor Tim Bale, Professor of Politics at Queen Mary University of London explores party-switching politics – including how many people switch allegiances and why they do so.
Breakthrough into leading cause of blindness13 July 2021
A team of scientists, including researchers from Queen Mary University of London, has discovered that the most common form of adult blindness is probably caused by a failure of at least one of five proteins to regulate the immune system.
Future UK trade agreements need to be compatible with its obligations on climate change, according to new report13 July 2021
Ahead of the UK hosting COP 26 later this year, the Trade Justice Movement and Queen Mary University of London are calling for the UK government to ensure that trade agreements help rather than hinder climate action.
Queen Mary and the English Speaking Union of Pakistan partner to boost education and research in Pakistan13 July 2021
Queen Mary University of London has entered into a prestigious partnership with the English Speaking Union of Pakistan. In signing this Memorandum of Understanding, Queen Mary will jointly improve access to education in Pakistan and help young people improve not only their lives, but potentially those of generations to come.
When it comes to research evaluations, peer reviews and bibliometric analysis should be viewed as complementary rather than determinate, according to new paper12 July 2021
New research from Queen Mary University of London suggests that when it comes to large-scale research evaluations such as the Research Excellence Framework (REF), peer reviews would be more cost-effective if targeted to publications not appearing in outstanding journals.
New HIV centre set up to tackle inequality and improve treatment12 July 2021
A new HIV research centre is being set up by Queen Mary academics to address health inequalities and improve quality of life for everyone affected by HIV.
AI predicts diabetes risk by measuring fat around the heart 7 July 2021
A team led by researchers from Queen Mary University of London has developed a new artificial intelligence (AI) tool that is able to automatically measure the amount of fat around the heart from MRI scan images.
Queen Mary’s landmark partnership with National Polytechnic Institute of Mexico cemented in latest meeting6 July 2021
Professor Colin Bailey, Queen Mary’s President and Principal met with the Principal of the National Polytechnic Institute, Mexico, Professor Arturo Reyes, to secure a historic relationship between the two institutions.
Professor Sir Mark Caulfield appointed as CEO of Barts Life Sciences1 July 2021
Professor Sir Mark Caulfield has been announced as the new Chief Executive Officer of Barts Life Sciences.
Queen Mary's People's Palace Projects open video installation in Glasgow ahead of COP2630 June 2021
Researchers from People's Palace Projects at Queen Mary University of London are set to exhibit their work at the Glasgow Science Centre ahead of COP26.
Queen Mary Students Complete ‘Virtual’ Parliamentary Placements30 June 2021
Another group of Queen Mary politics students have had the chance to work with an MP as part of their degree programme. Due to the Covid-19 pandemic, for the first time ever, the placements have been held entirely online.
E-cigarettes more helpful than nicotine replacement treatments for dependent smokers30 June 2021
E-cigarettes are more effective than nicotine replacement treatments in achieving long term smoking reduction and cessation, according to the results of a clinical trial by Queen Mary University of London.

29 June 2021
Dr Sydney Calkin, Lecturer in Human Geography at Queen Mary University of London discusses the recent abortion reform in Gibraltar.
New book provides unique and fascinating record of life under lockdown29 June 2021
People pose in their doorways, holding a range of possessions - dumbbells and dartboards, guinea pigs and gardening tools, accordions and artwork. These are just some of the images captured in a new book, Life Under Lockdown, which provides a unique insight into life during the Covid-19 pandemic.

28 June 2021
By Elizabeth Mantilas, Head of Admissions
Deciding where to study is a decision no student takes lightly. It takes a lot of research and consideration of many factors.
Queen Mary academic contributes to major report on urban violence25 June 2021
Dr Ashvin Devasundaram from Queen Mary University of London has contributed to a new report from the British Academy on the theme of urban violence.
Shoshana Zuboff on The Age of Surveillance Capitalism23 June 2021
The Institute for the Humanities and Social Sciences (IHSS) at Queen Mary University of London has held its Annual Symposium. Delivered by Professor Shoshana Zuboff, the event addressed the topic of her recent and influential book The Rise of Surveillance Capitalism.
New mouth cancer centre to improve survival and quality of life for thousands of patients23 June 2021
A new cancer centre is being set up to improve survival rates and quality of life for thousands of people affected by squamous cancer – a specific type of cancer which affects the mouth, skin, lungs and cervix.
Queen Mary researchers part of international team shortlisted for Cancer Grand Challenges awards
22 June 2021
Researchers from Queen Mary University of London have been selected to share their ideas on how they would solve one of cancer’s toughest challenges.

21 June 2021
Professor Sophie Harman, Professor of International Politics at Queen Mary University of London and colleagues, discuss the importance of global vaccine equity in this article for the Conversation.
First nationwide study reveals millions of cancelled operations due to COVID-19 and high risk of death18 June 2021
The first nationwide study of the impact of COVID-19 on surgery at NHS hospitals has revealed that more than 1.5 million operations were cancelled or postponed during the pandemic and surgical patients who became infected with COVID were five times more likely to die.

18 June 2021
By Lucie Langley, Faculty Education Manager, Humanities and Social Sciences
University can have a tremendously positive impact on people and communities in all areas of life. It provides opportunities to enrich expertise and allows students to find and build on their great passions. Here we take a look at two Queen Mary students who have made the best of the experience.

17 June 2021
In this article for the Conversation, Queen Mary PhD researcher Liam Nash shares the findings of a recent study that sheds new light on insect population declines in tropical regions.
Queen Mary academic receives prestigious science learning award16 June 2021
Professor Fran Balkwill OBE, Professor of Cancer Biology at Queen Mary University of London, has been announced as the 2021 winner of the Beetlestone Award which recognises leadership and legacy in the field of informal science learning.
Queen Mary’s School of Business and Management recognised as a leader in public good14 June 2021
The Chartered Association of Business Schools has published its latest report which recognises the School of Business and Management at Queen Mary University of London as a leader in delivering public good.
NHS Health Checks are not helping people who need them most14 June 2021
According to a seven year study led by researchers at Queen Mary University of London, involving more than three million people, only 8 per cent of those at greater risk of heart disease who would benefit from taking statins, were prescribed them.
Queen Mary University of London launches new degree programme14 June 2021
Queen Mary University of London has today (Monday 14 June), with PricewaterhouseCoopers (PwC) and the Institute of Chartered Accountants in England and Wales (ICAEW), launched a new degree in accountancy and joined PwC’s Flying Start Degree Programme.
Could your smart watch alert you to risk of sudden death?9 June 2021
Researchers have developed an algorithm that could ultimately enable smart watches to alert wearers to potentially deadly changes in their heart rhythm. The research, presented at the British Cardiovascular Society conference, could help to identify people at risk of sudden death.
Queen Mary alumna wins BAFTA for Best Single Drama7 June 2021
Stella Corradi has won a BAFTA for Best Single Drama for her film Sitting in Limbo, which was inspired by the Windrush scandal.

7 June 2021
Professor Tim Bale, Professor of Politics, with the School of Politics and International Relations has written an opinion piece for The Conversation on the G7 summit, Joe Biden’s first trip to the UK as US President, and what we can expect from his meeting with Boris Johnson.
Procedure using ultrasound energy found to treat high blood pressure7 June 2021
A minimally-invasive procedure that targets the nerves near the kidney has been found to significantly reduce blood pressure in hypertension patients, according to the results of a global multicentre clinical trial led in the UK by researchers at Queen Mary University of London and Barts Health NHS Trust.

4 June 2021
Dr Cameron Watson, Junior Doctor and Dementia Researcher, Wolfson Institute of Preventive Medicine, Queen Mary University of London has written an opinion piece for The Conversation on COVID-19’s impacts on the brain and mind.
More than 1 in 4 healthcare workers seek mental health support during Covid3 June 2021
The harsh impact of the Covid pandemic on healthcare workers’ mental, physical, and emotional wellbeing has been laid bare in a study showing how the impact intensified the longer the pandemic dragged on.
World Environment Day – How Queen Mary research is helping to protect the planet 3 June 2021
For World Environment Day (5 June), we take a look at some of the groundbreaking research from across Queen Mary's Faculty of Science and Engineering that is helping to improve global understanding of environmental challenges, restore ecosystems and support sustainable development.
Arabic people nearly 50 times more likely to be stopped and scanned by police, according to new report3 June 2021
A report published by Queen Mary University of London reveals major racial disparities in police Stop and Scan practices.
The trade system is key to tackling climate change, not environmental agreements, according to new book2 June 2021
A new book authored by an academic from Queen Mary University of London provides a radical new insight into how climate change can be tackled by using the trade system.

1 June 2021
Brigitte Granville, Professor of International Economics and Economic Policy at Queen Mary University of London has written an opinion piece for The Conversation on the recent concerns about serious inflation damaging the global economy.
Quark-gluon plasma flows like water, according to new study27 May 2021
What does quark-gluon plasma – the hot soup of elementary particles formed a few microseconds after the Big Bang – have in common with tap water? Scientists say it’s the way it flows.
Queen Mary launches new research project to tackle safety concerns with zero emission vehicles27 May 2021
Queen Mary University of London researchers have been awarded funding from the Engineering and Physical Sciences Research Council to develop new, lightweight and low-cost materials for the manufacture of safer zero emission vehicles.

27 May 2021
Dr Magda Osman, Reader in Experimental Psychology at Queen Mary University of London, provides her perspective on this question in an article for the Conversation's new series, Life’s Big Questions, co-published with BBC Future.
Radar tracking uncovers mystery of where honeybee drones have sex 20 May 2021
Scientists from Queen Mary University of London and Rothamsted Research have used radar technology to track male honeybees, called drones, and reveal the secrets of their mating behaviours.
Queen Mary researchers exhibit at the 17th International Architecture Exhibition – The Venice Biennale19 May 2021
Researchers from People's Palace Projects at Queen Mary University of London are set to exhibit their work at the Venice Biennale.
Having a healthier heart is associated with better problem-solving and reaction time14 May 2021
People with healthier heart structure and function appear to have better cognitive abilities, including increased capacity to solve logic problems and faster reaction times, according to research led by Queen Mary University of London and the Radcliffe Department of Medicine at University of Oxford.

13 May 2021
Dr Philippa Williams, Reader in Human Geography at Queen Mary University of London has co-written an opinion piece for The Conversation about the roll out of WhatsApp’s new privacy policy, which critics warn will lead to more data sharing with its parent company Facebook. The piece was co-written with Dr Lipika Kamra from O.P. Jindal Global University.

13 May 2021
Professor of International Politics at Queen Mary, was originally published in The Conversation and discusses the US agreement to support a waiver of the Trade Related Intellectual Property Rights (TRIPs).
#MentalHealthAwarenessWeek: Improving our understanding of mental health, resilience and well-being13 May 2021
For Mental Health Awareness Week, we’re taking a closer look at how researchers at Queen Mary University of London are undertaking to better understand mental health and potentially find new ways to treat mental health conditions.
Schools of History and Law receive gender equality awards13 May 2021
Queen Mary University of London’s School of History and School of Law have both been awarded the prestigious Athena Swan Bronze Award by Advance HE.
New poll reveals that the NHS, jobs and mental health are the public’s top priorities for rebuilding after Covid-1912 May 2021
A study from academics at Queen Mary University of London's Mile End Institute examines public opinion and the commitment to ‘build back better’.

12 May 2021
, a PhD Researcher from Queen Mary's School of Politics and International Relations, has written an opinion piece for The Conversation about Sadiq Khan's re-election and his plans for the next three years.
Three Queen Mary scientists elected to prestigious fellowship12 May 2021
Three scientists from Queen Mary University of London have today been elected to the highly prestigious Academy of Medical Sciences Fellowship.
Exploring Keir Starmer’s leadership of Labour one year on11 May 2021
The Mile End Institute at Queen Mary University of London has brought together a panel of experts to discuss Keir Starmer’s first year as Leader of the Opposition in the aftermath of the major elections that took place in Scotland, Wales and other parts of the UK.

11 May 2021
To mark Mental Health Awareness Week, Communications Manager Joel Winston speaks to Dr Mark Freestone, Reader in Mental Health at Queen Mary University of London, about 'post-lockdown anxiety' and how people can manage their worries about socialising and returning to work.
Scientists catch exciting magnetic waves in action10 May 2021
Researchers have confirmed the existence of magnetic plasma waves, known as Alfvén waves, in the Sun’s photosphere.
People’s Palace Projects hosts groundbreaking digital performance of The Tempest7 May 2021
The online performance of the Shakespeare play was an adapted production in response to Covid-19, featuring young Peruvian people with autism.
Queen Mary researchers help to tackle vaccine hesitancy in schools7 May 2021
Queen Mary researchers have been working with schools to design resources to help young people better understand immunisation programmes.

6 May 2021
Professor Seán McConville from Queen Mary's School of Law has written an opinion piece for The Conversation on the history of the so-called dirty protests which took place in some prisons in Northern Ireland during the Troubles.
Arbitration still seen as the best process for resolving international disputes, even in times of pandemic6 May 2021
International arbitration is overwhelmingly the favoured option for dispute resolution, according to the International Arbitration Survey published by Queen Mary University of London.
Queen Mary researchers win prestigious design award for innovative sea turtle behaviour simulator6 May 2021
Atlantis, a sea turtle behaviour simulator co-created by Queen Mary researchers and designers at Wolf in Motion, has won the IF award for User Experience design.
Queen Mary opens new life science business incubation space in Whitechapel5 May 2021
Queen Mary University of London has announced the official opening of Queen Mary Enterprise (QME), a new innovation space in the heart of Whitechapel in east London.
Prior SARS-CoV-2 infection rescues B and T cell responses to variants after first vaccine dose30 April 2021
A single dose of vaccine boosts potent responses against SARS-CoV-2 coronavirus variants in those with previous COVID-19, a study has found.
Brexit, Digital Platforms and Algorithms: Exploring Competition Policy in the UK29 April 2021
Competition policy has become a central issue in economics and politics around the world, particularly in light of recent investigations into the practices of large technology companies. These topics were debated at a recent event hosted by the Mile End Institute at Queen Mary University of London.

29 April 2021
Postdoctoral Researcher at Queen Mary's William Harvey Research Institute, was originally published in The Conversation and discusses the advantages that draft scientific papers ('preprints') have brought to COVID-19 research during the pandemic.
Queen Mary researcher awarded funding from the Institute for Catalan Studies28 April 2021
The Generalitat de Catalunya prize, totalling more than €4,000, was awarded to Richard Huddleson, a recent PhD graduate from Queen Mary’s Centre for Catalan Studies.
Researchers develop new smell test for Parkinson’s, Alzheimer’s and COVID-1928 April 2021
A new smell test developed by Queen Mary University of London researchers has been found to be easy to use in patients with Parkinson’s disease, and could also be helpful in diagnosing COVID-19 in the broader population.
Talented Early Career Researchers join Queen Mary on STFC-funded fellowships26 April 2021
Dr Kirsty Duffy and Dr Michèle Levi have been awarded Ernest Rutherford Fellowships from the Science and Technology Facilities Council (STFC) to establish their own innovative research programmes at Queen Mary University of London.
The Queen Mary academic who uncovered inequalities in the way Britain commemorated its war dead23 April 2021
Professor Michèle Barrett from Queen Mary’s School of English and Drama found a document which instructed that black and Asian troops from World War One were to be commemorated collectively whilst their white counterparts had headstones.

23 April 2021
Dr Patrick Diamond, Senior Lecturer in Public Policy at Queen Mary University of London has written for The Conversation about how Keir Starmer recently celebrated his first year as leader of the Labour party.
Queen Mary historian wins Templer Medal book prize22 April 2021
Professor Dan Todman from Queen Mary’s School of History won the book competition, organised by the Society for Army Historical Research, for his bestselling book on World War II.
New research to study impact of air pollution on children’s brain development and mental health22 April 2021
Queen Mary University of London researchers have been awarded a £300,000 grant to study the impact of air pollution on children’s brain function and mental health.
Queen Mary academic awarded major European Research Council grant22 April 2021
Professor Warren Boutcher, Acting Head of the School of English and Drama at Queen Mary University of London, has been awarded more than €2million by the European Research Council (ERC).
Queen Mary to launch women-only MRes with the Autonomous University of Baja California to tackle gender inequality in STEM21 April 2021
Queen Mary University of London has signed an agreement with the Autonomous University of Baja California in Mexico to develop a women-only Dual Master of Research programme (MRes) in Science and Engineering to help address gender inequality in science, technology, engineering, and mathematics (STEM).
Queen Mary researchers to help unlock the potential of marine wave energy16 April 2021
Queen Mary University of London have launched a new research project aimed at overcoming current challenges with devices that capture wave energy and convert it into electricity.
Scientists uncover secret of the hunger switch in the brain15 April 2021
A 3D structure reveals how a unique molecular switch in our brain causes us to feel full – and may help develop improved anti-obesity drugs.
Study strengthens links between red meat and heart disease15 April 2021
An observational study by Queen Mary University of London researchers in nearly 20,000 individuals has found that greater intake of red and processed meat is associated with worse heart function.

13 April 2021
Dr Patrick Diamond, Director of Queen Mary's Mile End Institute (MEI) has written an opinion piece for The Conversation on Sadiq Khan's chances in the upcoming Mayor of London elections. His analysis is based on recent polling commissioned by the MEI.
Queen Mary researcher awarded fellowship to develop a new generation of digital musical instruments12 April 2021
Dr Andrew McPherson has been awarded a Senior Research Fellowship by the Royal Academy of Engineering to improve the richness and nuance of digital musical instruments.
Researchers discover new way to starve brain tumours12 April 2021
Scientists from Queen Mary University of London, funded by the charity Brain Tumour Research and the Medical Research Council, have found a new way to starve cancerous brain tumour cells of energy in order to prevent further growth.
Queen Mary students and staff celebrate International Women’s Day at online event9 April 2021
For International Women’s Day, Queen Mary University of London's WISE@QMUL group hosted a two-day virtual conference to celebrate women in Science, Technology, Engineering, Maths and Medicine (STEMM).
Mile End Institute poll sheds light on Londoners' views on Labour one year into Keir Starmer’s leadership9 April 2021
Almost half of Londoners believe the UK Labour party is divided, according to a new survey from the Mile End Institute at Queen Mary University of London.
Half of Londoners likely to have Covid jab if offered, according to latest Mile End Institute poll 8 April 2021
As the UK’s vaccination programme continues, results from the latest Mile End Institute poll for Queen Mary University of London suggest that half of Londoners are likely to have a Covid-19 vaccination if offered to them.
New poll predicts Sadiq Khan on course for victory in London mayoral election
7 April 2021
Sadiq Khan is cruising to a convincing victory in the forthcoming mayoral election contest in London, according to an exclusive new poll carried out for the Mile End Institute at Queen Mary University of London.
How preprints accelerated science communication during the pandemic7 April 2021
A new study led by Queen Mary University of London researchers has found that during the early phase of the pandemic, approximately 35 per cent of the COVID-19 scientific literature was shared as preprints – freely available manuscripts that are shared prior to peer-review in a journal.
Queen Mary to celebrate launch of new dual Masters programme with joint event6 April 2021
On 15 April 2021, Queen Mary University of London and Mexico’s Research Centre for Advanced Materials (CIMAV) will host a joint event to mark the launch of their new MRes programme in Materials Science.
Prisoners not politicians were key to the Good Friday Agreement succeeding, according to new book1 April 2021
Irish Political Prisoners 1960-2000 by Seán McConville from Queen Mary University of London provides one of the most comprehensive accounts of the Northern Ireland troubles to date.
Political developments in France offer sharp lessons for the rest of Europe, according to new research1 April 2021
A new book authored by an academic from Queen Mary University of London offers fresh insights into politics and society in France, providing a critique of French leadership in the run-up to the forthcoming presidential elections.
Study provides first evidence of DNA collection from air31 March 2021
Researchers from Queen Mary University of London have shown for the first time that animal DNA shed within the environment can be collected from the air.
Queen Mary ranks as a leader in Research England’s first Knowledge Exchange Framework31 March 2021
Queen Mary University of London's role as a leader in knowledge exchange has been recognised in the inaugural Knowledge Exchange Framework published by Research England.
Building resilience among people with autism30 March 2021
Researchers from Queen Mary University of London are collaborating with a range of stakeholders, including theatre companies and healthcare workers, to support people with autism through a unique project, Heartbeat – Creating Recovery.
Parliament should take the lead on constitutional reform in the UK according to Lord Chancellor29 March 2021
Queen Mary University of London has hosted a major conference exploring the successes and failures of constitutional reform in the UK. Lord Chancellor Rt Hon Robert Buckland QC MP delivered the keynote speech, setting out the delicate balance that is required between institutions as the constitutional system continues to evolve.

26 March 2021
Dr Lucy Bolton, Reader in Film Studies at Queen Mary University of London has written for The Conversation about the work of Virginia Woolf and the impact that cinema had on her.
New genetic clues point to new treatments for ‘silent’ stroke 26 March 2021
Scientists from Queen Mary University of London have helped identify new genetic clues in people who’ve had small and often apparently ‘silent’ strokes that are difficult to treat and a major cause of vascular dementia.
Unique research programme investigates how arts-based methods can support the NHS staff during Covid-1925 March 2021
The project will support those working in health to meet the challenges of wearing Personal Protective Equipment (PPE), and adapting to digital consultations and meetings.
Queen Mary joins NIHR School to strengthen primary care research25 March 2021
The NIHR (National Institute for Health Research) has announced the fourth phase of the School for Primary Care Research (SPCR), which now involves Queen Mary University of London, and a new focus on supporting the full spectrum of primary care research and building research capacity.
Queen Mary Professor nominated to UN International Law Commission24 March 2021
Professor Phoebe Okowa has been nominated to the United Nations' International Law Commission by the Government of Kenya.
Dementia death risk is higher among the socioeconomically deprived23 March 2021
A large proportion of dementia deaths in England and Wales may be due to socioeconomic deprivation, according to new research led by Queen Mary University of London.
New podcast offers an insight into real life experiences at home during lockdown23 March 2021
Stay Home Stories, a project led by academics from Queen Mary University of London, has launched its first podcast of people’s experiences of home during the Covid-19 pandemic.
Queen Mary Professor turns detective for new BBC Radio 3 show22 March 2021
Jerry Brotton, Professor of Renaissance Studies at Queen Mary University of London is presenting a new ten-part series for BBC Radio 3’s The Essay.
22 March 2021
Rowena Hill, a PhD student at Queen Mary University of London and the Royal Botanic Gardens, Kew, has written a piece for the Conversation about a newly-discovered hidden world of fungi inside the world's biggest seed bank.
Queen Mary honours Catherine Silverstone with posthumous promotion17 March 2021
Queen Mary University of London has promoted Catherine Silverstone from the School of English and Drama to Professor, the first posthumous promotion of its kind at the University.
Scientists develop new approach to predict how liquids freeze17 March 2021
Researchers from Queen Mary University of London have developed a novel computational approach to better understand freezing in different types of liquids.
Scientists develop rapid test for diagnosis of rare set of genetic conditions17 March 2021
Researchers at Queen Mary University of London and Cardiff University have developed a rapid test for the diagnosis of a constellation of rare and debilitating genetic conditions, which is described as a ‘step-change’.
Arts and Culture Queen Mary launches its Conversations Week17 March 2021
Queen Mary University of London is set to hold a week-long celebration of the art of conversation which will run from 9 to 16 April.
Subsidies most effective way to encourage sustainable food choices, study shows17 March 2021
Subsidising low carbon emission meals could encourage more people to choose them, according to new research.
Queen Mary support new UK-India consortium to address global sustainability challenges
16 March 2021
Scientists from the UK and India have set up multi-disciplinary virtual platform for international collaboration on global sustainability challenges, such as carbon reduction and environmental remediation.

16 March 2021
Dr Richard Johnson, Lecturer in US Politics in Queen Mary's School of Politics and International Relations has written an opinion piece for The Conversation about Irish Americans and US foreign policy. He argues that US security interests will always come above personal identities.
Democracy under threat as climate emergency deepens, according to Mile End Institute panel11 March 2021
The Mile End Institute at Queen Mary University of London has hosted a webinar on democracy and climate change. Panellists included Hilary Benn, former Secretary of State for Environment, Food and Rural Affairs, and Caroline Lucas MP, former leader of the Green Party.
Queen Mary graduate helping to save the planet using seaweed11 March 2021
Marcos Souto Ulloa, a graduate from Queen Mary University of London, has developed a revolutionary material made from seaweed aimed at preventing plastic seeping into the world’s oceans.
Schools reopening without robust COVID-19 mitigation risks accelerating the pandemic10 March 2021
A group of academics have set out a series of recommendations for schools to reduce the risk of COVID-19 transmission now that they have re-opened, in a letter published in The Lancet.
Having an unhealthy heart could lead to a higher risk of being diagnosed with COVID-199 March 2021
People with unhealthy heart structures and poorer functioning hearts have a significantly higher risk of being diagnosed with COVID-19 infection, according to research by Queen Mary University of London, in collaboration with the Medical Research Council Lifecourse Epidemiology Unit (The University of Southampton).
Scientists’ discovery ends long-standing photosynthesis controversy9 March 2021
New findings overturn conventional thinking about the location of a key plant enzyme involved in photosynthesis.
Convincing evidence that type 2 diabetes is associated with increased risk of Parkinson’s8 March 2021
Research from Queen Mary University of London has concluded that there is convincing evidence that type 2 diabetes is associated with an increased risk of Parkinson’s disease.

8 March 2021
Sandra Eldridge is Professor of Biostatistics and Director of the Pragmatic Clinical Trials Unit at Barts and The London School of Medicine and Dentistry, Queen Mary University of London. In this blog post, Professor Eldridge discusses the recent excitement around some promising clinical trial results that suggest that vitamin D improved the recovery of hospitalised COVID-19 patients, and she explains why the trial may be flawed.
Queen Mary teams up with leading law firms to deliver Executive Education course8 March 2021
The Centre for Commercial Law Studies at Queen Mary University of London has launched its first ever International Asset Tracing and Recovery Executive Education course.
BAFTA nominated film produced by Queen Mary academic released for International Women’s Day7 March 2021
Pili, a feature length drama about living with HIV/AIDS in East Africa, has received its multi-territory release to coincide with International Women’s Day.
New book explores how the sea continues to shape political and economic forces around the world5 March 2021
A new book co-authored by an academic from Queen Mary University of London sheds light on the maritime origins of capitalism, as well as the political economy, ecology and geopolitics of the sea.
Significant gender disparities revealed in COVID-19 clinical trial leadership5 March 2021
Less than one-third of COVID-19 clinical trials are led by women, which is half the proportion observed in non-COVID-19 trials, according to research led by Queen Mary University of London, University of St Andrews, Brigham and Women's Hospital and Harvard Medical School.
Queen Mary graduate employability stats reveal our unique approach helps students get ahead
4 March 2021
Queen Mary graduate outcomes show our students leave university ready to take their place in an ever-evolving jobs market.
Queen Mary student nominated for BAFTA Rising Star Award3 March 2021
Conrad Khan, a student from Queen Mary’s School of Languages, Linguistics and Film is among the five nominees.
Attending consecutive mammography screens protects against breast cancer death3 March 2021
Attending the two most recent screening appointments before a breast cancer diagnosis protects against breast cancer death, according to a Queen Mary study of over half a million Swedish women conducted over 24 years.
Alumni Angles: A conversation with BBC newsreader, Jane Hill2 March 2021
On Thursday 25 February, the Alumni Engagement Team launched their flagship engagement series ‘Alumni Angles’ to showcase the talent in the Queen Mary alumni community.
Queen Mary to launch dual degree programme for Masters in Materials Science with Mexico’s CIMAV2 March 2021
Queen Mary University of London will launch a Masters in Materials Science (MRes) pathway this month for students with the Research Centre for Advanced Materials (CIMAV) headquartered in Chihuahua, Mexico.
Secrets of sealed 17th century letters revealed by dental X-ray scanners2 March 2021
In a world first, an international team of researchers has read an unopened letter from Renaissance Europe – without breaking its seal or damaging it in any way.
Queen Mary academic to lead film collaboration in South Africa2 March 2021
Dr Ashvin Devasundaram from Queen Mary’s School of Languages, Linguistics and Film will lead the inaugural South African edition of the Young Curators Lab.
Global warming poses threat to food chains1 March 2021
Rising temperatures could reduce the efficiency of food chains and threaten the survival of larger animals, new research shows.

1 March 2021
Professor Philip Cowley from Queen Mary's School of Politics and International Relations has written an opinion piece for The Conversation in which he argues that the work that MPs do in their constituencies is important and deserves proper study.
Queen Mary awarded funding from Advance HE’s Collaborative Development Fund for education project1 March 2021
Queen Mary University of London has secured funding from Advance HE's Collaborative Development Fund Education theme for the project "Developing flexible ecosystems for education that support student success: where are we now, what works and where next?"

1 March 2021
Professor Kiera Vaclavik from Queen Mary's School of Languages, Linguistics and Film has written an opinion piece for The Conversation in which she argues that reading aloud can be a seductive act. Kiera Vaclavik is Professor of Children's Literature & Childhood Culture in the Department of Comparative Culture and Literature.
Single dose of vaccine acts as ‘booster’ in those with prior COVID-19 infection26 February 2021
People who have previously had COVID-19 have an enhanced antibody response with a single dose of RNA vaccine, according to a study of 51 UK healthcare workers, around half of whom had a previous laboratory-confirmed SARS-CoV-2 infection.
Researchers to explore the impact of the coronavirus pandemic on domestic abuse referrals in primary care25 February 2021
A new study involving researchers from Queen Mary University of London will explore whether and how GP referrals to domestic abuse services have changed during the coronavirus pandemic.
New tool reveals security and privacy issues with contact tracing apps25 February 2021
Researchers have developed a tool to identify security and privacy risks associated with Covid-19 contact tracing apps.
New funding for storytelling project to inspire future engineers24 February 2021
A Queen Mary project has received funding to continue to bring the art of digital and immersive storytelling into the world of science and engineering.
Pandemic is changing the way militaries operate and are perceived in the health space, according to new research23 February 2021
A new study authored by a researcher at Queen Mary University of London has shed new light on how militaries act as health responders in the wake of the Covid-19 pandemic.
Salt reduction will prevent nearly 200,000 cases of heart disease and save £1.64bn 22 February 2021
England’s salt reduction programme will have led to nearly 200,000 fewer adults developing heart disease and £1.64 billion of healthcare cost savings by 2050, according to research by Queen Mary University of London.
New book explores the impact of EU trade agreements on workers’ rights18 February 2021
A new book, co-authored by academics from Queen Mary University of London, explores the contentious relationship between trade and labour, and the impact of the EU’s ‘new generation’ free trade agreements on workers.

17 February 2021
Dr Ronan Lee, Visiting Scholar at Queen Mary's International State Crime Initiative has written an opinion piece for The Conversation in which he explains how the Myanmar military have been able to take advantage of the Covid-19 pandemic.
New study shows that men receive more actionable feedback than women in the workplace16 February 2021
A new study led by an academic from Queen Mary University of London has shed light on the way in which women's advancement into senior leadership roles remains slower than men's.
New class of drug leads to 30 per cent reduced risk of death for bladder cancer patients12 February 2021
A new type of drug that helps target chemotherapy directly to cancer cells has been found to significantly increase survival of patients with the most common form of bladder cancer, according to results from a phase III clinical trial led in the UK by Queen Mary University of London and Barts Health NHS Trust.
Celebrating Queen Mary Women in Science11 February 2021
The UN International Day of Women and Girls in Science (11 February) aims to recognise the critical role women and girls play in science and technology communities.
Government report draws on evidence from Queen Mary10 February 2021
Evidence from Queen Mary has been cited in a new government report from the House of Commons Women and Equalities Committee.
New research project set to explore the role of civil society in supporting migrant populations during the Covid-19 pandemic4 February 2021
Academics from Queen Mary University of London have been awarded funding from the University’s Strategic Research Priorities Fund to undertake a cross-regional study exploring the role of civil society organisations supporting vulnerable migrant populations in Brazil and India in the context of Covid-19.
Scientists propose new way to detect emotions using wireless signals3 February 2021
A novel artificial intelligence (AI) approach based on wireless signals could help to reveal our inner emotions, according to new research from Queen Mary University of London.
Professor Kimberly Hutchings appointed as chair of a Research Excellence Framework panel 3 February 2021
The four UK funding bodies have appointed Professor Kimberly Hutchings from Queen Mary's School of Politics and International Relations as chair of Sub-panel 19: Politics and International Studies for the forthcoming Research Excellence Framework (REF 2021).
Submissions now open for the Queen Mary Wasafiri New Writing Prize 20211 February 2021
Representing more of the globe than any other prize of its kind, the Queen Mary Wasafiri New Writing Prize is opening its doors for 2021 and welcoming work in fiction, poetry, and life writing from unpublished writers around the world.
More symptoms need to be included in UK case definition of COVID-191 February 2021
Runny nose (coryza) and other indicative symptoms should be added as possible signs of COVID-19 infection, so that more people can access NHS covid tests, according to a Queen Mary academic writing in The BMJ, in an open letter to the Chief Medical Officer, supported by 140 east London general practitioners and health care professionals.
Queen Mary research featured as an impact case study by UK Research and Innovation1 February 2021
Research from Queen Mary University of London’s People’s Palace Projects has been selected as a case study by UK Research and Innovation (UKRI) to showcase the impact of its Global Challenges Research Fund (GCRF).
Consuming omega-3 fatty acids could prevent asthma28 January 2021
New research suggests that a higher dietary intake of long chain omega-3 fatty acids in childhood may reduce the risk of developing subsequent asthma, but only in children carrying a common gene variant. The study, led by Queen Mary University of London, is in collaboration with the University of Bristol and University of Southampton, UK, and Karolinska Institutet, Sweden.
New study suggests that the financial impact of Covid-19 is comparable to the Wall Street Crash of 192927 January 2021
A study co-authored by an academic from Queen Mary University of London has shed new light on the true magnitude of the impact of the Covid-19 pandemic on financial markets.
Commuting patterns could explain higher incidence of Covid-19 in Black Americans27 January 2021
The disproportionately high Covid-19 infection rates observed in Black Americans could be linked to their daily commuting patterns, according to a new study published today in the Journal of the Royal Society Interface.
Professor Fiona Walter joins Queen Mary as Institute Director26 January 2021
Professor Fiona Walter has been appointed as the new Joint Director of the Wolfson Institute and Institute for Population Health Sciences, Queen Mary University of London.
Queen Mary researchers to trial drug to protect against COVID-19 exposure26 January 2021
Researchers at Queen Mary University of London and Barts Health NHS Trust are looking for clinical trial participants who have recently (within 8 days) been in contact with someone who has tested positive for Covid-19.
Study provides first real-world evidence of Covid-19 contact tracing app effectiveness26 January 2021
An international research collaboration, involving scientists from the UK, US and Spain, has shed new light on the usefulness of digital contact tracing (DCT) to control the spread of Covid-19.
Study sheds new light on the behaviour of the giant carnivorous dinosaur Spinosaurus as a monstrous heron26 January 2021
New research from Queen Mary University of London and the University of Maryland, has reignited the debate around the behaviour of the giant dinosaur Spinosaurus.
Patients from Asian and black backgrounds are more likely to die from COVID-19, large study reveals22 January 2021
Patients of Asian and black backgrounds suffered disproportionate rates of premature death from COVID-19, according to a study of 1,737 patients by Queen Mary University of London and Barts Health NHS Trust.
Investigating COVID-19 in Black, Asian and minority ethnic communities21 January 2021
A new study led by Queen Mary University of London and Barts Health NHS Trust, and funded by Barts Charity, seeks to understand why Black, Asian and Minority Ethnic communities are so badly affected by the COVID-19 virus and address the lower uptake of the vaccine by people in these groups.
Queen Mary students show high levels of satisfaction21 January 2021
A new survey has revealed that students from Queen Mary’s Language Centre have high levels of satisfaction when it comes to Pre-Sessional courses.
Scientists find black holes could reach ‘stupendously large’ sizes20 January 2021
A recent study suggests the possible existence of ‘stupendously large black holes’ or SLABS, even larger than the supermassive black holes already observed in the centres of galaxies.
COVID-19 testing lab goes online at Queen Mary14 January 2021
A new COVID-19 testing lab at Queen Mary University of London has started processing NHS Test and Trace samples from the UK population, to increase the country’s testing capacity.

14 January 2021
Professor Andrew Pollard, Director of the Oxford Vaccine Group, studied Medicine at Barts and qualified in 1989. He recently spoke to the Queen Mary Alumni team to talk more about his studies here and provided an insight into the development of the Oxford-AstraZeneca vaccine, which is now being rolled-out to the most vulnerable people in the UK and globally.
Ancient DNA from extinct dire wolves reveals their unique evolutionary history13 January 2021
Extinct dire wolves split off from other wolves nearly six million years ago and were only a distant relative of today’s wolves, according to new research.

6 January 2021
Dr Magda Osman, Reader in Experimental Psychology at Queen Mary University of London has written an opinion piece for The Conversation exploring whether freedom passes based on negative test results could offer a way to avoid placing restrictions on everyone.
Queen Mary expands stop smoking service to Newham residents5 January 2021
As people start their New Year’s resolutions, a free stop smoking service has launched in the London Borough of Newham, provided by experts at Queen Mary University of London.
Alumni Angles: A conversation with BBC newsreader, Jane Hill